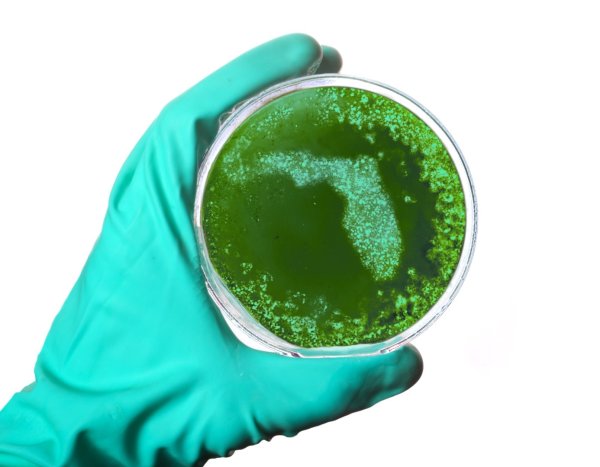

While it would make sense that, during wars populations decrease, that doesn't happen in aggressor nations.
Celebrating Inclusivity: Yuletide vs. Christmas
Lest we forget our past, the one before Jesus, we must remember it again, every winter solstice, even if for a few seconds.
9/11 Images You May Not Have Seen
Displaying more than 250 photographs from before and after 9/11/01.
Remembering Walter: A Life Well-Lived
To have loved once in life is a miracle for many, but to have loved twice?
Hero Gun Owners?
Nobody feels good about where we're at, not even gun enthusiasts.
Elegy for George Floyd
I woke when I saw George Floyd go limp. In my day, snuff films didn’t exist.
Post-Pandemic Normal: A Forecast of Sorts
When Mother Earth sent us humans to the corner ... she sent us us the possibility that we won’t return to normal until 2022.
Vets Voice First Show
Game Breaker was a true psychological trauma story cut in a massively comedic light.
Rust Departs
Peter Rust, 78 and mayor of Davenport for 16 years until 2013, passed away yesterday.
The Birthday
Surely, how one has lived one's life is a testament to a person’s existence, but the manner of one's own death? Is that also a testament of one's life?
On Reserving Judgment
She could neither change places nor things, a requisite for surviving any addiction.